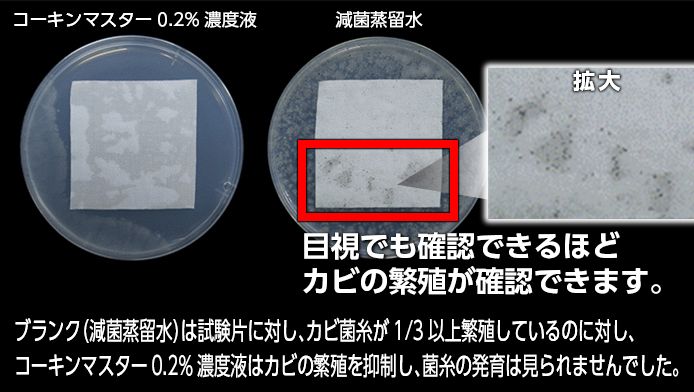

特集 コーキンマスターとは
コーキンマスターとは
性能が異なる4種の抗菌剤・防カビ剤を配合した複合系抗菌剤です。
作用点が異なるので、細菌だけでなく効果が出にくい真菌(カビ)、繁殖力の高い酵母菌にも有効です。またダニの増殖抑制にも効果があります。
有効成分を一定量(0.2%)入れたものをコーキンマスターとして製品化しています。

コーキンマスターパウダー

抗菌・防臭性能
【抗菌】

【防臭】
汗をかいた際、発生する繊維のツーンとした臭い・・・
実は、汗の臭いではなく、汗を栄養として菌が繁殖した時の臭いが原因です。
コーキンマスターの制菌性能で菌を減らし、臭いの元から防臭効果を発揮いたします。
防カビ性能
【試験先】一般財団法人カケンテストセンター
【試験方法】JIS Z2911カビ抵抗性試験法 湿式試験準用
【試験期間】2016年2月17日 14日間
【試験布】綿100%平織白布
【試験菌】
クロコウジカビ Aspergillus niger NBRC105649
アオカビ Penicillium citrinum NBRC6352
ケタマカビ Chaetomium globosum NBRC6347
木材腐朽菌 Myrothecium verrucaria NBRC6113
【試験液】
コーキンマスター有効成分0.2%濃度を45℃にて6ヶ月保管液
ダニの増殖抑制性能
【試験方法】 JIS L1920ダニ増殖抑制A法(準用)
人体安全性
コーキンマスターはSIAA(抗菌製品技術協議会)
SEK(繊維製品技術評価協議会)の検査項目基準クリア。
・急性経口毒性試験とは
一般的に化学薬品の安全性は、急性経口毒性試験で試験します。
マウスやラットの体重あたりの投与量(mg/kg)で示したLD50値が高い程安全な薬剤となります。
コーキンマスター水分散体0.2%濃度液は、LD50 5000mg/kgの基準をクリアしております。
パッチテスト結果
日本人成人20名に抗菌カビパンチスプレーのパッチテスト(閉塞貼付)を実施した結果
香粧品の皮膚刺激指数0評価にて、「安全品」分類されています。

日本人成人20名に黒カビパンチのパッチテスト(閉塞貼付)を実施した結果
香粧品の皮膚刺激指数0評価にて、「安全品」分類されています。



